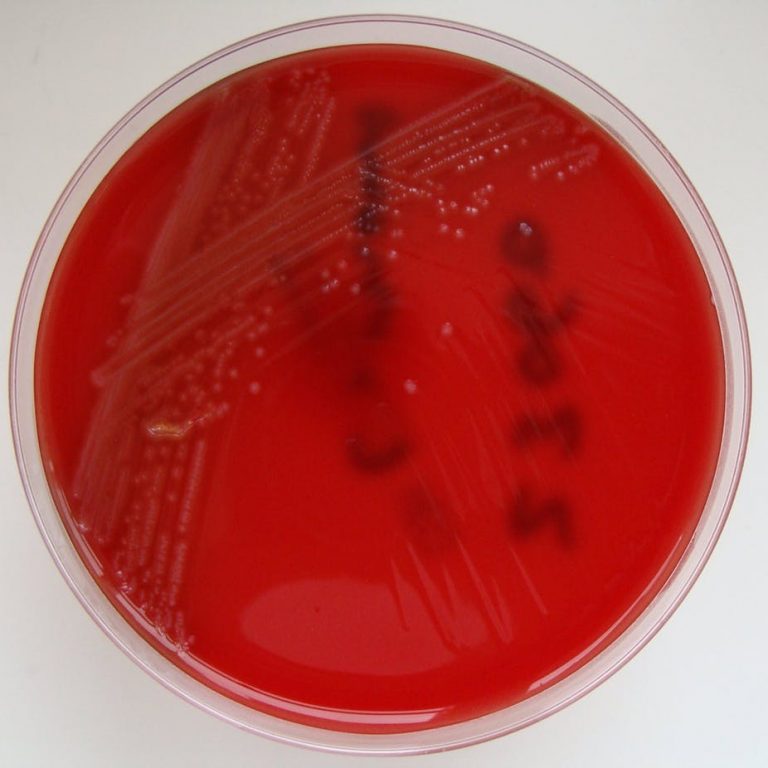
What led to world’s worst listeriosis outbreak in South Africa

The South African Reserve Bank has placed a small bank – VBS Mutual Bank – under curatorship. The decision was based on concerns that the bank was facing a liquidity crisis and could collapse, devouring depositors’ funds. Some have criticised the decision. Sibonelo Radebe from The Conversation Africa asked Jannie Rossouw to explain the process.
What is curatorship?
In simple terms curatorship of a bank means that its board and executive management are relieved of their duties. A curator is appointed by the South African Reserve Bank in consultation with the National Treasury and the Minister of Finance. The curator takes over the full management functions of the bank with the purpose of rehabilitating it.
Curatorship is triggered by concerns about the management or financial viability of the bank. For example, if the board or executive management are found guilty of fraud, the central bank can remove them and appoint a curator to manage the bank until new management is put in place.
Financial viability concerns can trigger curatorship if a bank faces liquidity or solvency problems. This is what happened at VBS. The central bank’s view was that it faced a liquidity crisis – in other words it was running short of cash to meet its obligations, mainly repayment of deposits.
Liquidity problems happen when bank deposits are withdrawn at a faster rate than they can be replaced by new deposits. This is normally a temporary problem, as a well functioning bank can restore its liquidity levels by taking in new deposits or by reducing its lending activities.
Banks can also face solvency problems. This is different to a liquidity crunch: it’s when a bank goes bust because loans it has made can’t be repaid. In 2001 a South African bank, Regal Treasury Bank went insolvent.
Although the South African Reserve Bank can still appoint a curator when a bank experiences solvency problems, the chances of recovery are slim. This was the case with Regal Treasury Bank which was placed under curatorship but never recovered. It was subsequently liquidated.
Is there an alternative to curatorship?
The alternative to curatorship is liquidation which involves winding down the operations of a bank.
Whereas curatorship is primarily aimed at rehabilitating the operation, liquidation is all about closing it down.
If a bank can’t meet its commitments (and a curator isn’t appointed speedily to save the situation), it’s likely to go bust and head straight into liquidation.
A bank can re-emerge from curatorship, but not from liquidation.
An example of successful rehabilitation after when a curator was appointed is African Bank. After being placed under curatorship in 2014, it developed into a healthy operation again. Curatorship in this case helped to restore confidence in the bank.
This is likely to apply in the case of VBS because it remains fully operational. At the same time its employees – but not the board members and the executive management – are protected as they still have their jobs. This would not be the case if the bank was forced to close.
Was curatorship the right answer for VBS?
Yes, without any doubt. VBS is a perfect example of a bank being saved from liquidation through curatorship. If the bank was not placed in curatorship, it would have had to be liquidated and forced to shut up shop. This would have meant job losses.
The reason VBS got into trouble was that it took deposits it shouldn’t have. As a mutual bank, registered under the Mutual Banks Act of 1993, it should not have accepted deposits from municipalities because the Municipal Finance Management Act of 2003 prohibits it.
Only commercial banks registered in terms of the Banks Act of 1990 may accept deposits from municipalities. In taking deposits from municipalities, VBS contravened a law that protects the financing of local government authorities. The law doesn’t allow mutual banks to accept municipal deposits. The aim is to mitigate risks for both the bank and the municipalities.
Taking deposits from municipalities was also inviting liquidity problems for VBS. As the South African Reserve Bank governor put it:
It was highly risky for VBS to take sizeable municipal deposits that were short-term and lend them out long term.
This meant that there was a mismatch between the bank’s deposits and its exposure to loans it was giving out.
Once it was established that VBS had broken the law, it was ordered to return the municipality deposits. This put it under even more pressure from a liquidity point of view.
The board and executive management of VBS are to blame for the problems at the bank and for its curatorship. They were in clear dereliction of their duties in accepting municipal deposits in the first instance. Accepting these deposits was in clear contravention of the law – something the board, the executive management and the compliance officer should never have agreed to. They should be taking the blame for the curatorship rather than to try and blame others. They might even have to face charges.
Fortunately, VBS is a very small bank in the South African banking landscape and its impact is too small to have triggered a systemic banking crisis. It is also reassuring to note the continuation of employment of the staff members of VBS Bank.
Read the original article here